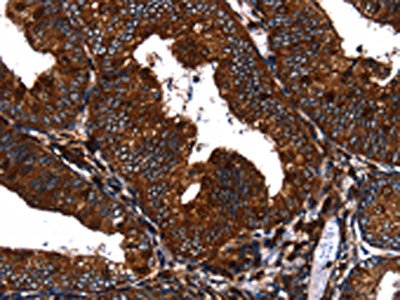

EGF Antibody
-
中文名稱:EGF兔多克隆抗體
-
貨號:CSB-PA942209
-
規格:¥1100
-
圖片:
-
其他:
產品詳情
-
Uniprot No.:
-
基因名:
-
別名:Beta urogastrone antibody; beta-urogastrone antibody; EGF antibody; EGF_HUMAN antibody; Epidermal growth factor antibody; HOMG4 antibody; OTTHUMP00000219721 antibody; OTTHUMP00000219722 antibody; Pro epidermal growth factor antibody; URG antibody; Urogastrone antibody
-
宿主:Rabbit
-
反應種屬:Human
-
免疫原:Fusion protein of Human EGF
-
免疫原種屬:Homo sapiens (Human)
-
標記方式:Non-conjugated
-
抗體亞型:IgG
-
純化方式:Antigen affinity purification
-
濃度:It differs from different batches. Please contact us to confirm it.
-
保存緩沖液:-20°C, pH7.4 PBS, 0.05% NaN3, 40% Glycerol
-
產品提供形式:Liquid
-
應用范圍:ELISA,IHC
-
推薦稀釋比:
Application Recommended Dilution ELISA 1:1000-1:5000 IHC 1:50-1:200 -
Protocols:
-
儲存條件:Upon receipt, store at -20°C or -80°C. Avoid repeated freeze.
-
貨期:Basically, we can dispatch the products out in 1-3 working days after receiving your orders. Delivery time maybe differs from different purchasing way or location, please kindly consult your local distributors for specific delivery time.
-
用途:For Research Use Only. Not for use in diagnostic or therapeutic procedures.
相關產品
靶點詳情
-
功能:EGF stimulates the growth of various epidermal and epithelial tissues in vivo and in vitro and of some fibroblasts in cell culture. Magnesiotropic hormone that stimulates magnesium reabsorption in the renal distal convoluted tubule via engagement of EGFR and activation of the magnesium channel TRPM6. Can induce neurite outgrowth in motoneurons of the pond snail Lymnaea stagnalis in vitro.
-
基因功能參考文獻:
- Our results show that the chimeric EGFETA toxin is extremely effective against EGFRpositive cancers and raises the potential to further develop this chimera for use in targeting EGFRpositive tumours resistant to monoclonal antibodies. PMID: 30226622
- These results highlight the potential role of EGF in promoting hepatocellular carcinoma (HCC) metastasis, demonstrate a novel pathway for regulation of FN expression and provide potential targets for HCC prevention and treatment. PMID: 29315755
- The abnormally elevated expression of EGF and TGF-alpha are closely associated with the occurrence and development of chronic pancreatitis and pancreatic cancer PMID: 29125273
- ERRa positively regulated the cell proliferation, migration and invasion of colon cancer cells, and the suppression of ERRa completely reduced the EGF treatment-induced proliferation of colon cancer cells. PMID: 30185207
- EGF significantly upregulated RFPL3 and hTERT protein levels in the nonsmall cell lung cancer cells. RFPL3 and hTERT proteins upregulation by EGF were attenuated by pretreatment with AG1478 and erlotinib. EGF promoted proliferation and inhibited apoptosis; PD98059 decreased RFPL3 and hTERT protein expression; and RFPL3 overexpression increased the expression of hTERT and related MEKpathway proteins. PMID: 29749533
- we have discovered the novel N-72, and it was crucial for EGF-induced migration by targeting MMP2 in Human amnion mesenchymal stem cells (hAMSCs) PMID: 29734654
- The spleen can regulate the functions of hematopoietic stem cells in cirrhotic hypersplenism by regulating EGF signaling. PMID: 29721775
- After HIP1 expression was blocked by siRNAs, EGFR endocytosis was accelerated and this effect was dependent on the EGF concentration. This endocytosis was colocalized with clathrin expression. These findings indicate that the inhibition of HIP1 can accelerate the endocytosis and degradation of EGFR PMID: 29039605
- the present study demonstrated that EGF induced aggressiveness of gastric cancer cells by activating epithelial to mesenchymal transition, which involved the activation of the ERK1/2 pathway and, subsequently, uPAR expression PMID: 28849196
- the EGF system is a mechanosensitizer in bone marrow stromal cells. PMID: 28843157
- EGF counteracts Tat modulation of human endogenous retroviruses of the W family in astrocytes. PMID: 28474333
- FTIR spectra of EGF, unconjugated, post treatment with alpha-lipoic acid, attached to gold nanoparticle, and bound to the bifunctional nanoprobe, showed decreasing disordered structures and turns, and increasing loops, as the synthesis process progressed. There was an overall increase in beta-sheets in final product compared to pure EGF, but this increase was not linear and fluctuated. PMID: 29122663
- EGF-mediated lysosome trafficking, protease secretion, and invasion is regulated by the activity of p38 mitogen activated protein kinase (MAPK) and sodium hydrogen exchangers (NHEs). Interestingly, EGF stimulates anterograde lysosome trafficking through a different mechanism than previously reported for HGF, suggesting that there are redundant signaling pathways that control lysosome positioning PMID: 28978320
- Although the diabetic chronic wounds microenvironment is hostile for local GFs bioavailability, EGF local infiltration circumvented the limitations of its topical application, thus expanding its therapeutic prospect. Our clinical pharmacovigilance and basic studies attest the significance of the GF local infiltration for chronic wounds healing. PMID: 28904952
- these results provide the first evidence for an association between the EGF rs2298999 C/T polymorphism and gout PMID: 27506295
- The increased EGFR expression revealed in patients with seborrheic keratomas (SK)and concomitant (type 2 diabetes mellitus (DM2))is caused by insulin resistance and hyperinsulinemia, in which the dysregulation of insulin signal transmission into the cell leads to changes in EGF synthesis and signaling pathway that regulates cell proliferation and growth. PMID: 28791994
- novel EGFR-NF-kappaB-FOXC1 signaling axis that is critical for BLBC cell function PMID: 28629477
- EGFR pathway gene expression analysis indicated that DeltaNp63 alters EGFR-regulated genes involved in cell adhesion, migration, and angiogenesis. Addition of EGF or neutralizing EGFR antibodies demonstrated that EGFR activation is responsible for DeltaNp63-mediated loss of cellular adhesion PMID: 28349272
- EGF up-regulated CCL2 expression in HNSCC cells, which recruited monocytes and turned them into M2-like macrophages, thus forming a positive feedback paracrine loop. PMID: 27888616
- this study shows that EGF induces epithelial-mesenchymal transition through phospho-Smad2/3-Snail signaling pathway in breast cancer cells PMID: 27829223
- EGF and TNFalpha cooperatively promoted the motility of HCC cells mainly through NF-kappaB/p65 mediated synergistic induction of FN in vitro. These findings highlight the crosstalk between EGF and TNFalpha in promoting HCC, and provide potential targets for HCC prevention and treatment. PMID: 28844984
- Data suggest that EGF induces colorectal cancer cells to undergo epithelial-mesenchymal transition, enhances their ability to invade/migrate, and promotes phosphorylation of Ezrin at Tyr353. (EGF = epidermal growth factor) PMID: 28535417
- Simulation results indicate that human epidermal growth factor receptor (hEGFR) soluble soluble extracellular domains (sECD):EGF show different dynamic properties between the two pHs, and the complex may have a higher tendency of activation at pH 8.5. PMID: 27179806
- EGF and IP-10 were significantly elevated and GRO levels were lower in the tear profile of HIV patients with dry eye disease (DED) compared to immunocompetent patients with DED. PMID: 27585367
- Data (including data from studies using transgenic/knockout mice) suggest that surfactant protein A1 (SPA1) interferes with EGF binding to EGFR in pulmonary alveoli cell lines; SPA1 directly binds extracellular domain of EGFR; binding of SPA1 to EGFR appears to be different from binding of SPD to EGFR; binding of SPA1 to EGFR does not suppress EGF-induced phosphorylation of EGFR or cell proliferation. PMID: 28972165
- EGF-AREG interplay in airway basal cell stem/progenitor cells is one of the mechanisms that mediates the interconnected pathogenesis of all major smoking-induced lesions in the human airway epithelium. PMID: 27709733
- caspase-3 inhibitors also suppressed the attenuation of cell adhesion and phosphorylation of p38 MAPK by EGF-F9. Our data indicated that EGF-F9 activated signals for apoptosis and induced de-adhesion in a caspase-3 dependent manner. PMID: 27129300
- evidence that CDK1/2 participate in the regulation of constitutive pre-mRNA splicing by EGF stimulation in MDA-MB-468 cells. PMID: 27109354
- The EGF rs4444903 GG genotype is associated with higher susceptibility to HCV-related liver cirrhosis and hepatocellular carcinoma in the Chinese Han population PMID: 28397482
- TGF-beta opposes EGF-mediated sensitization to TRAIL-induced caspase-8 activation and apoptosis in non-transformed breast epithelial cells. EGF and TGF-beta finely regulate sensitivity of human breast epithelial cells to TRAIL which may be relevant during morphogenesis. PMID: 27208428
- Amplification of the EGFR gene can be maintained and modulated by variation of EGF concentrations in in vitro models of glioblastoma multiforme PMID: 28934307
- Our study showed that the EGF61 rs4444903GA genotype had a decreased risk of non-syndromic cleft lip with or without cleft palate. Our data provides further evidence regarding the role of EGF61 variations in the development of non-syndromic cleft lip with or without cleft palate in families of the studied populations PMID: 28906376
- Interestingly, EGF rapidly downregulates LINC01089 (here renamed LncRNA Inhibiting Metastasis; LIMT) expression by enhancing histone deacetylation at the respective promoter. PMID: 27485121
- EGF-induced, calpain-mediated proteolysis contributes to the rapid destruction of cyclin G2 and that the PEST domain is critical for EGF/calpain actions PMID: 28640887
- The salivary levels of EGF are significantly increased during the acute phase of natural rotavirus infection. PMID: 28558652
- findings have identified a role for members of these signaling pathways in the regulation of EGF-induced vimentin expression in the MDA-MB-468 breast cancer cell line PMID: 27163529
- miR-223 downregulated the local expression of epidermal growth factor (EGF), leading to decreased activation of EGF receptor (EGFR) on target cells and, eventually, dampening a positive EGF-EGFR autocrine/paracrine stimulation loop induced by the post-surgical wound-healing response. PMID: 26876200
- EGFR and EGF expression showed no significant difference between placentas from normal pregnancies and those complicated with preeclampsia. PMID: 27657362
- Atomistic molecular dynamics simulations show that N-glycosylation of the EGFR extracellular domain plays critical roles in the binding of growth factors, monoclonal antibodies, and the dimeric partners to the monomeric EGFR extracellular domain. PMID: 28486782
- CMTM3 decreases EGFR expression, facilitates EGFR degradation, and inhibits the EGF-mediated tumorigenicity of gastric cancer cells by enhancing Rab5 activity. PMID: 27867015
- Findings suggest EGF not only promotes the proliferation of adipose stem cells and delays their senescence, but also maintains the differentiation potency of adipose stem cells, which are related to the EGF-induced activation of STAT signal pathway. PMID: 28746211
- The results show that the interaction between STS-1 and ShcA is regulated in response to EGF receptor activation. PMID: 28690151
- Insulin treatment caused sustained Akt activity, whereas EGF or PDGF-AA promoted transient signaling; PDGF-BB produced sustained responses at higher concentrations.Transient responses to EGF were caused by negative feedback at the receptor level, as a second treatment yielded minimal responses, whereas parallel exposure to IGF-I caused full Akt activation PMID: 27044757
- our results indicate that different concentrations of bFGF and EGF supplemented during propagation of neural rosettes are involved in altering the identity of the resultant neural cells. PMID: 27321088
- F25P preproinsulin effectively reduced the concentrations of EGF, VEGF, and MMP-9 in the blood of tumor-bearing mice with EGFR-mutant glioblastoma. PMID: 27317648
- Conformational stability of the EGFR as influenced by glycosylation, dimerization and EGF hormone binding has been described. PMID: 28019699
- Differential expression patterns of EGF, EGFR, and ERBB4 are essential in epithelial restitution and remodeling in nasal epithelium. PMID: 27285994
- Phosphorylation and immunohistochemical assays on the EGF receptor in HeLa cells indicate the EGF protein produced in soybean seed is bioactive and comparable to commercially available human EGF. This work demonstrates the feasibility of using soybean seeds as a biofactory to produce therapeutic agents in a soymilk delivery platform. PMID: 27314851
- Data suggest that activated platelets release ADAMDEC1, which hydrolyzes pro-EGF (epidermal growth factor) to soluble, active HMW-EGF; proteolytic cleavage of pro-EGF first occurs at the C-terminal arginyl residue of the EGF domain; proteolysis is the regulated, rate-limiting step in generating soluble EGF from activated platelets. PMID: 28455445
- Subgroup analysis in a Slovak population by gender showed the genotype EGF G61G and allele G was associated with non significantly increased risk of MDD. PMID: 27755861
顯示更多
收起更多
-
相關疾病:Hypomagnesemia 4 (HOMG4)
-
亞細胞定位:Membrane; Single-pass type I membrane protein.
-
組織特異性:Expressed in kidney, salivary gland, cerebrum and prostate.
-
數據庫鏈接:
Most popular with customers
-
-
YWHAB Recombinant Monoclonal Antibody
Applications: ELISA, WB, IHC, IF, FC
Species Reactivity: Human, Mouse, Rat
-
Phospho-YAP1 (S127) Recombinant Monoclonal Antibody
Applications: ELISA, WB, IHC
Species Reactivity: Human
-
-
-
-
-